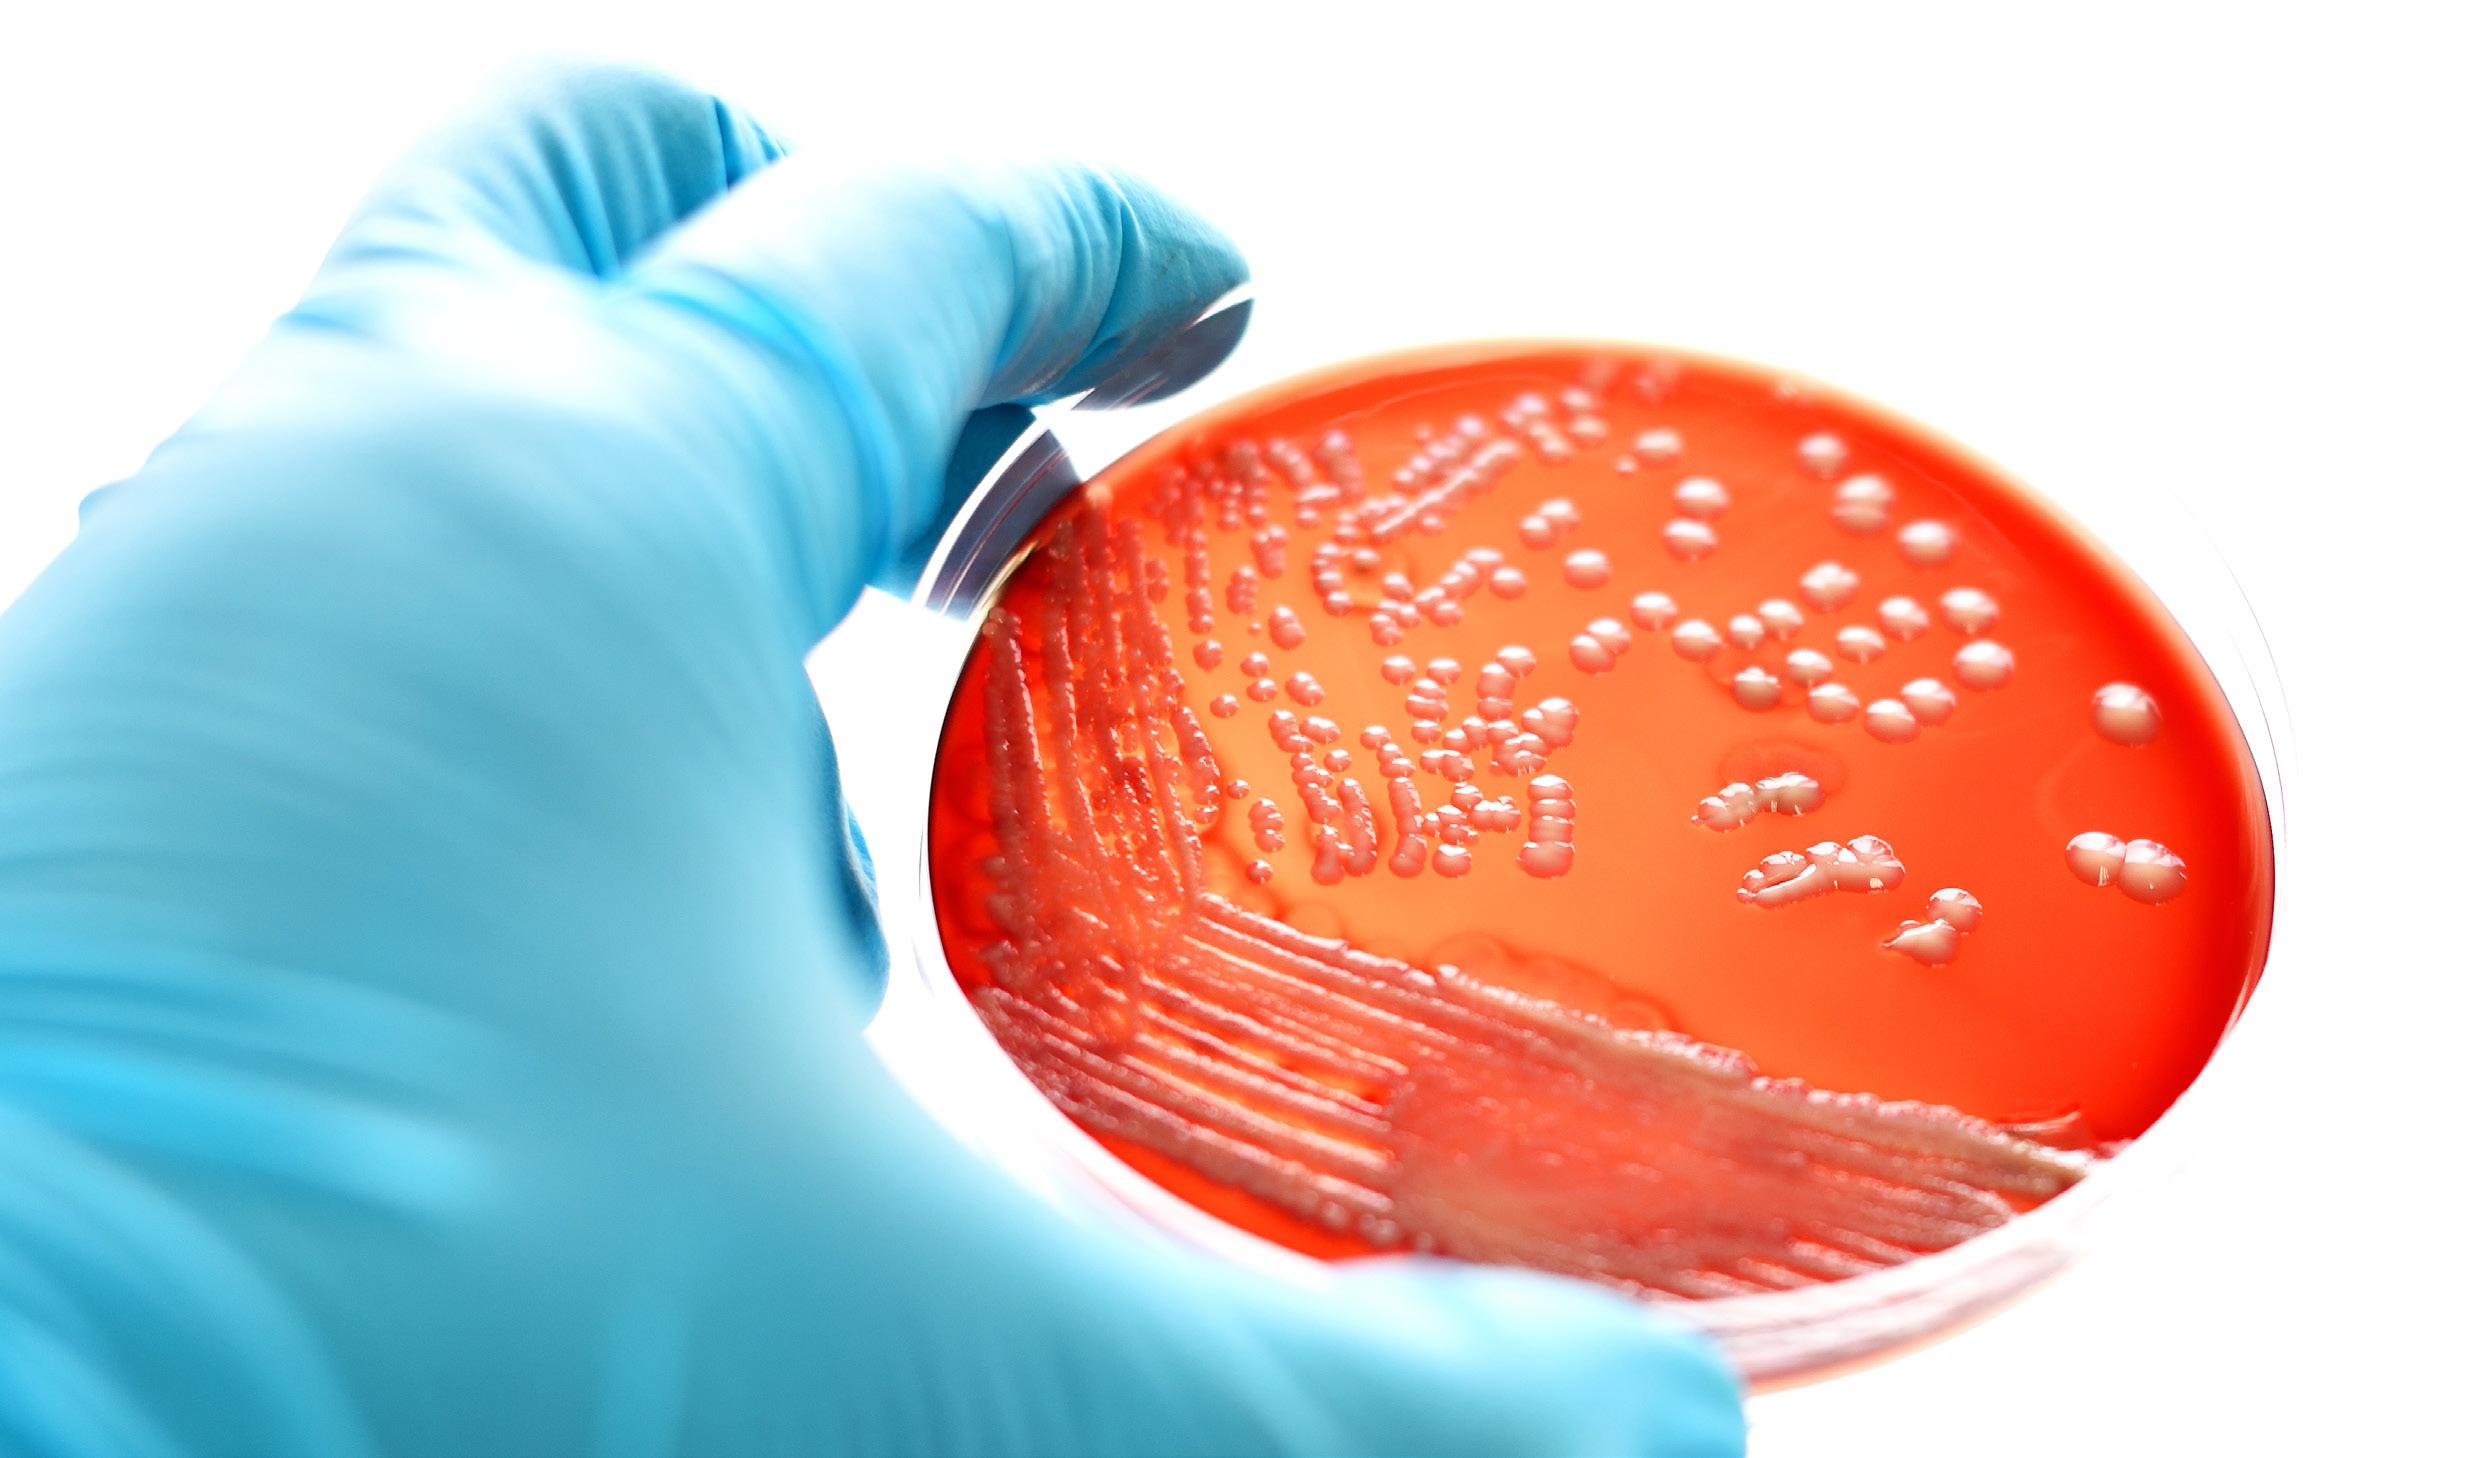

![]()

























Priserne går op og op, i hvad der ligner en evig himmelflugt. Derfor arbejder vore dygtige indkøbere konstant med at indkøbe smartere og billigere - og gerne mere lokalt, der hvor det giver mening. Vi sætter også gerne kvaliteten op uden at prisen stiger.
Med “fair pris” symbolet fejrer vi de små sejre. Er varen blevet billigere for os, så bliver den billigere for vores kunder.

Derfor ser du heller ikke vilde tilbudsaviser og udsalg hos Scandidact. Du kan regne med, at varen koster det den koster - til den bliver billigere for os i indkøb.
Det synes vi er mest fair.
Hold øje med sparegrissymbolet og se, når vi fejrer, at vi har indkøbt smartere og billigere... - for os og for jer!













Scan QR koderne i kataloget med kameraet eller QR-app’en på din smartphone og hent





















Vi har udviklet på vores populære Chlorella-alger og de er nu tilbage i et nyt og ukompliceret kit - med endnu mere læring til dine elever!
Vær med i hele processen, når I poder, mikser og dyrker jeres egen Chlorella i vores nye praktiske gør-det-selv algekit. Den færdige algekultur kan anvendes til undervisning i:
• Fotosyntese
• Vækstbetingelser og næringsstoffer
• Klimavenlig madproduktion
• Superfood
• Mikroskopi
Du får alt hvad du skal bruge til et læringsrigt forløb, inkl. udførlige øvelsesvejledninger til både grundskole og STX-niveau.
Hvid Chlorella, 200g pulver
Brug Hvid Chlorella i madlavning i tværfaglige forløb med fokus på bæredygtighed, klima og superfood. Avlet fri for klorofyl og dermed fri for den grønne farve og karakteristike smag, men med de samme sunde næringsmæssige egenskaber.
Anvend den i al slags bagværk, mad og drikke - det er kun fantasien, som sætter grænserne for hvordan du kan bruge algepulveret.






Overvåg nemt vandværdierne i saltvandsmiljøer med denne praktiske kuffert, der indeholder alt hvad I skal bruge til at udføre 11 tests af f.eks. værdierne for pH, carbonathårdhed, calcium, magnesium, kobber, ammonium, nitrit, nitrat, phosphat, silikat, ilt m.m..
Det er utrolig let at bruge sættet, hæld blot vand i kuvetten, tilføj indikator, sammenlign på skala / tæl dråber, indtil farven ændrer sig. Sammenligningssystemet tager hensyn til vandets naturlige farve.

Der medfølger i alt 29 reagenser, 12 glasbeholdere, 2 plastikkuvetter, 2 sprøjter, 3 måleskeer, termometer, pen, rapport- og analyseark, samt udførlig vejledning til både folkeskole og stx-niveau.
Sættet kan efterfølgende genopfyldes enkeltvis.
Simpel saltvands-testkuffert til analyse af pH, fosfat, carbonathårdhed, ammoniak, ammonium, nitrit og nitrat.








- planter fra sø og dam
Praktisk bestemmelsesdug i farver trykt på en kraftig vinyldug med pædagogisk inddeling og detaljerede illustrationer. Dugen måler 110x110 cm.

God og formstabil kvalitet, der er velegnet til indsamling, iagttagelse, og sortering.
Komfortable waders med god slidstyrke, refleksstriber på ben, fixlock-lukning, sømværn og ståltåkap.
ophæng
Løs udfordringen med opbevaring og tørring med praktiske ophæng.

Scan QR koden med kameraet på din smartphone og hent

øvelsesvejledning til indsamling af vandplanter


Smuk naturplakat med de mest almindelige dyr og planter, der lever i søer og åer.




Turbiditetsrør, 60cm
Perfekt til måling af vandprøver under feltarbejde, udflugter eller eksperimenter. Kan anvendes til måling af vandkvalitet og turbiditet (uklarhed) i søer og åer, i afstrømningsvand fra markarealer eller til vurdering af humus mængden i vandet.

Ekstra bundprop (reservedel)
Med en erstatnings-bundprop behøver du ikke smide dit turbiditetsrør ud - skulle uheldet være ude.

Akvarium/terrarie/faunaboks med håndtag og foderlem. Velegnet til både indsamling, opbevaring og transport.


Sigtbarhedsplade/Secchiskive Praktisk sort/hvid udgave på 410 g til søer uden meget strøm. Inkl. lille nøgle med 3 m kraftig fiskeline, samt plastikvindsel med 100 m nylonline.




Professionelt planktonnet med 180 µm til indsamling og observation af små vanddyr. En stærk netdug er spændt ud og forstærket med bomuldsstof på en kraftig ring. Net diameter 30 cm, dybde 89 cm, plastikbeholder 5 cm dyb.
Kastenet med 10mm maskestørrelse og lodder af stål til fangst af agnfisk, småfisk og andet. 150cm i højden med 8 meter reb med håndledsløkke. Maskestørrelse 10mm.


120 cm skaft i asketræ, ø16 cm
150 cm skaft i asketræ, ø20 cm
Med krydsforstærkning for ekstra holdbarhed. 120 cm skaft i asketræ, ø16 cm
150 cm skaft i asketræ, ø20 cm


Klassisk dafnienet i forbedret udgave med forstærkning og et fintmasket net, der er ideelt til dafnier og andre små vanddyr. Ø27 cm, 120 cm coated bambusskaft og totallængde 147 cm.


Perfekt som grejkasse til ekskursioner og forsøg i felten. De perforerede sider sikrer ventilation, så udstyret luftes og tørres og medvirker desuden til at kassen holder en forholdsvis lav vægt.
60 x 40 x 17
60 x 40 x 42
60 x 40 x 32 Låg, 60 x 40


Kasterive 40cm
Vandplanterive i rustfrit stål til indsamling af tang og vandplanter. Komplet med 20 meter line på vindsel.



Undgå lysets brydning i vandoverfladen og iagttag livet i vandet og på bunden – selv på større dybder. Udformet i robust plast, der holder i mange år.




Løftenet/krabbenet
Fungerer lidt ligesom en krebsebrik, men har højere sider. Måler 30cm i diameter.
OBS: Kræver lystfisketegn (dog ikke, hvis man er under 18 år eller over 65 år)
Scan QR koden med kameraet på din smartphone og hent

Rudestørrelse: 17 x 20 cm.
Stor model
Rudediameter 32 cm, højde 55 cm
øvelsesvejledning til indsamling af vandplanter






Danmarks største udvalg! Sid og gå på den - tør blot ren med en våd klud.

>> Smådyr i de ferske vande
>> Vandløbsbestemmelse
>> Planter fra sø og dam
>> Saltvandsdyr
>> Tang

>> Smådyr/insekter fra landjorden
>> Uglegylp dissektionsdug og bestemmelsesnøgle

>> Sten ved stranden
>> Sortering af sten
>> Sten/ledeblokke

>> Planter fra sø og dam
>> Skovens træer om vinteren

>> Dyrenes stamtræ
>> Evolution og klassifikation
Praktisk transport af bestemmelsesduge mv. i dette opbevaringsrør, der er monteret med praktisk justerbar bærestrop.

>> Skovens forårsblomster
>> Skovens svampe
>> >> >>
Raunkiær cirkel (1/10 m kvantitativ undersøgelse flora- og faunaforekomst.
OBS: nu i rustfrit stål!




Brug Phaunierne til masser af leg, læring og udvikling.
NATUR – RELATIONER – EVENTYR – SANKNING – RIM –TAL – MØNSTRE – SANSER – KREA MED MAD, DRIKKE & DEKORATIONER
En Phaunie (udtales Favni) er et lille eventyrligt væsen, der bor i skove, krat og haver, i parker og på altaner. Den er ikke større end en tommeltot, og den elsker at gemme sig, men vil i virkeligheden rigtig gerne findes og bruges til noget. Lidt ligesom mennesker.
Phaunierne er små væsener, der på eventyrlig vis, passer på og sørger for alle de gratis gaver, som vi kan finde og samle i naturen, og som vi kan bruge til at lave mad, drikke og dekorationer af. Der er f.eks en Brombær Phaunie, en Æble Phaunie og en Kastanje Phaunie.
Klar-parat-pakkerne fra Scandidact inkluderer:
• Inspirationshæfte med masser af aktiviteter til ude og indendørsaktiviteter

Bog: Det første Phaunie eventyr
Højtlæsningsbog fra 4-7 år.
I det første eventyr om Phaunierne går Agern Phaunie morgentur i efterårsskoven. Her møder den Brombær Phaunierne, som både spidser tornene og pynter sig. Den møder også sin ven Kastanje Phaunie, som føler sig helt farveløs og slet ikke klar til aftenens fest i hindbærkrattet. Mon det lykkes Agern Phaunie at få opmuntret sin ven, så de kan komme sammen til fest?
• 12 Phaunie plakater (A5, A4 eller A3)
• 12 Phaunie kort (A6) til at tage med på tur


Fire på Phaunie.



Til indsamling af insekter fra løv, træstamme m.m. Soldet består af to netringe, sammenholdt over hinanden af netposen. Den øverste netrings særlige udformning muliggør, at den kan slutte tæt til en træstamme.
Netdia. 27cm.

Den mest omfattende håndbog om insekter på dansk - mere end 1200 arter af insekter og leddyr er beskrevet. Arterne er vist med tegninger og oplysninger om størrelse, findetid, levested, hyppighed og andet. Bogen er forsynet med en nøgle til insekttyperne, afsnit om dyrenes opbygning og levevis, om indsamling, præparering og konservering samt et omfattende register.

Til indsamling af smådyr. Man suger i den ene slange og holder den anden mod det sted, hvor smådyrene findes. Et fint net forhindrer, at man får dyr i munden.

Praktisk bakke med 15 rum, der måler 6x6 cm. Meget nyttig når fangsten af smådyr og planter fra ekskursionen skal sorteres. Lave skillevægge, sikrer at sorteringen med ske, pincet eller pensel er nem og hurtig.


Flot insektnet / sommerfuglenet i høj kvalitet på kraftig ramme og med 76 cm skaft i poleret træ.
Insektkasser til præparation og display
Massivt fyrretræ med aftageligt glaslåg og løs flamingobund.
Mål 15x16x6 cm.

Mål 40x30x6 cm.

Stor og flot poleret træopbevarings- og displayboks med messinglåse. Mål 45x31x7 cm.




Pakker med 100 stk. til montering af insekter på spilebræt/spændebræt. Forskellige størrelser til både små-insekter, blåvinger og de store ligustersværmere og guldsmede.
Vælg mellem str. 000, 0, 1, 2, 3, 4, 5, 6 og 7.
Spændbræt/spilebræt med skumbræmme i rillen - beregnet til montering af insekter. Vælg mellem str. 000, 0, 1, 2, 3, 4, 5, 6 og 7.

Lille, let og handy heterodyn flagermusdetektor med baggrundsbelyst digitalt display, der viser den indstillede frekvens. Indstilling af frekvensen og volumen justeres på siden af flagermusdetektoren, hvilket gør betjeningen enkel og let. Detektoren kan bla. tilsluttes høretelefoner.

Ultralydscanning/optageenhed beregnet til langsigtet, uovervåget registrering af flagermuskald. I modsætning til andre ekspansion flagermusdetektorer, registreres hele spektret af ultralyd i realtid med næsten ingen forsinkelse. Optageren er udstyret med hele fire slots til CF-kort, som gør det muligt at efterlade enheden i området i mere end en måned. Udløsersystem der automatisk starter optagelsen.

Flagermusredekasse i høj kvalitet fra tyske Schwegler. Særligt velegnet til langørede flagermus, men også en god begynderkasse, for at teste, om der er flagermus i området.

Med denne USB-mikrofon sættes der en ny standard med fremragende følsomhed, lav støj. Trods sin lille størrelse, er det hele placeret i et slankt og slidstærkt aluminiumskabinet. Lavt strømforbrug, kombineret med en attraktiv pris gør denne model yderst populær.

Meget populær heterodyne og tidsekspansion-detektor med baggrundsbelyst digitalt display, der viser den indstillede frekvens i heterodyne mode. Nem regulering af frekvens og volumen på siden af detektoren. Ved hjælp af stereo hovedtelefoner, høres det heterodyne signal på den venstre kanal og tidsekspansion signal på den højre kanal.


Optag fra din flagermusdetektor og gem lydfilen til videre forarbejdning. Denne bærbare lydoptager leverer lyd af den kendte høje Roland-kvalitet og en lang række praktiske optagefunktioner, når man er på farten.


Genanvendelig dug i kraftig plast med anvisninger til dissektion. Dugen beskytter bordpladen og rengøres nemt.
Scan QR-koden og hent

øvelsesvejledning om muslingernes filtreringsevne udviklet i samarbejde med Naturpark Lillebælt


Dissektionssæt
Komplet sæt i æske. Kan stables og tages med i felten.


Dissektionsbakke
Kraftig formstabil kvalitet. Nem at rengøre. Mål: 37 x 27 x 6 cm.


Dissektionsbakke
Metalbakke med voks til at fæstne med f.eks. spilenåle.
Dissektionsdug, uglegylp
Dugen viser skelettyper, der typisk findes i uglens føde og gylp. På dugen vises fugleskelet, gnaverskelet og muldvarpeskelet, samt en bestemmelsesnøgle til jeres fund. Trykt i robust materiale, ligesom de klassiske bestemmelsesduge. Mål: B73cm x H60cm.


Redekasser til de mest almindelige danske fuglearter. Isolerende letbeton sikrer jævn temperatur på varme dage og kolde nætter.
Eks.
Gærdesmutte Spurve, mejser
Gråspurvekoloni

orro-prisme-design leverer kikkert med bredt synsfelt og en høj optisk kvalitet til en overkommelig pris, hvilket gør den til et fremragende valg for både begyndere og erfarne brugere.



Et must for fugleinteresserede! Efterligner ikke specifikke fuglestemmer, men skaber en støj, der tiltrækker de nysgerrige fugle. Effektiv, når man vil lokke fuglene til og få dem til at synge. God til sangfugle, men kan benyttes til alle småfugle.


Væk børnenes interesse for naturen - eller glæd en af dine kære, som ikke selv kan komme ud. Måske også den perfekte tilføjelse til hjemmekontoret?


Feltbøger og opslagsværk - se hele udvalget i webshoppen!



Håndtegnede af danske illustratorer. Brug plakaterne som dekoration i faglokalet eller institutionen og øv jer hver dag.






Sigteanordningen samler og forstærker lydbølgerne både tæt på og langt fra lydkilden - kan endda opfange lyd gennem et vindue.


Praktisk følgesvend til ekskursionen. Leveres med bærerem. Lup 5x.
Velegnet til ekskursioner for alle aldersgrupper. Lup 5x.



Lup med fokuseringsstøtte til frimærker, pengesedler, mønter, sten, bøger mm. Linse Ø 4,1 cm, bund 5 cm.


Botanikerlup med triplet linse. Lup 10x.

Klassisk forstørrelsesglas Ø 6 cm med håndtag, som måler 12,5 cm.


Kvadratisk beholder af blød plast. H11 cm. Glaslinse 5x er monteret i låget.

Spejle i luppen gør det mulig at se objektet fra flere sider. Lup 4x.

Praktisk mini-mikroskop med LED, som giver optimal belysning af genstanden. Lup 20x-40x.



Lav-selv-papir med denne støbeform med net.
Genanvend papirrester, æggebakker og lign. og lav jeres eget papir. Tilsæt evt. lidt flydende akvarelmaling, velduftende blade, lavendler, pressede blomster eller måske bladguld? Måler 20 x 30 cm.


Feltpresse af hårdttræ med nylonstropper holder pressen stramt sammen og metalklamper sikrer et stabilt og jævnt pres på planter og blomster. Mål 31 x 46 cm.

Håndtegnede af danske tegnere. Brug plakaterne som dekoration i faglokalet eller i hjemmet og øv jer hver dag.

Klassisk design med spænderulle i hårdt asketræ og presseplader i MDF. Ventilationshuller i pladerne nedsætter risiko for skimmel og mug og den øgede luftcirkulation giver hurtigere tørring. Rummer op til 100 stk. plantepressepapir


Eksempler:
Forårsskoven SKU312
Giftige bær SKU57
Giftige planter SKU56
Grøftekant SKU308
Hedeplanter SKU104
Lægeplanter SKU63
Nåletræer SKU65
Spiselige vilde planter SKU60
Spiselige blomster SKU108
Spiselige vilde frugter SKU59
Træer SKU64
Træernes blade SKU123


Husk at fylde lageret op med plantepressepapir, herbariepapir,


Et svampekort til feltbestemmelse, udarbejdet som en lille og handy folder. Sammenfoldet fylder kortet 8,5 x 16,5 cm.

Praktisk foldekniv med blød børste for enden, målestok og nøglering. Måler 17 cm udfoldet.

20 cm høj model af den smukke, giftige røde fluesvamp. Fremstillet håndlavet og -malet af anerkendte SOMSO ®, som producerer mange svampe og plantearter - kontakt os for flere priser.

Birkesaft kan tappes fra det tidspunkt safterne i birketræet begynder at stige. Det vil efter en typisk vinter være fra cirka midten af marts frem til at træerne springer ud i april. Med dette komplette sæt til tapning af birkesaft kan der tappes 4 dunke á 2,5 liter skøn, velsmagende og sund birkesaft. Indeholder: tappespand med hank og låg med hul (10 L), 4 stk 2,5 liters plastikdunke, en meter plastslange af PVC, tappestuds i messing, 2 stk. dyvler til at lukke hullet efter tapningen.
Tapningssæt Bag-in-box pose til opbevaring
Kompostdisplay til undervisning i biologisk nedbrydning, livscykler og miljø. 3 gennemsigtige rum gør det muligt at følge med i den biologiske nedbrydningsproces og sammenligne forskellige affaldsprodukter. Termometre viser temperaturudsving under nedbrydningen.



Undersøg respiration, nedbrydningsprocesser og stoffernes kredsløb. Jordrespirometret kan også anvendes, som en lille fotosyntesetank, hvor man kan måle på fotosyntesen hos f.eks. karse eller andre planter.



Få en succesfuld opstart i akvariehobbyen - tilsæt blot fisk, grus og akvarieplanter. Lyseffekt, varmelegeme og filterflow er valgt, så de passer perfekt til akvariernes størrelse.
Sættet inkluderer: belysning, filter, varmelegeme, plastiktop med foderluge, termometer, akvarienet, freebies fra Tropical
54 liter 60 x 30 x 30 cm
112 liter 80 x 35 x 40 cm
LED Expert-belysning 10W LED Expert-belysning 16W
Internt Claro filter (600 liter/time) Internt Claro filter (1000 liter/time) Justerbart varmelegeme 50W Justerbart varmelegeme 100W

BioBubble terrarie/ vækstklokke med LED-lys (værdi kr. 349,-) ved køb over kr. 5000,-.
Brug koden "BIOBUBBLE" ved bestilling.
OBS: begrænset oplag


Fiskene i et akvaponisk dyrkningssystem spiller en vigtig rolle, fordi de nedbryder fiskefoderet til små letopløselige partikler. Fisk forbruger meget mindre vand og foder pr. kg. kød end både grise og køer. Derfor er det bæredygtigt protein, så fremover kan vi komme til at spise mange flere fisk end vi gør i dag. Tilføj kun vand, fisk og jeres plantefrø og se det hele gro.

Akvarienet Algemagnet

Udforsk myrernes verden: myrer graver tunnelsystemer og planter spirer i et økosystem. Verdens første og eneste myrehabitat testet under nul-tyngdekraftsforhold af NASA. Gelen i myrehabitat indeholder alt, hvad myrerne har brug for af mad og næringsstoffer,
Plantarium gør det sjovt at se 3 forskellige planter vokse sig større - både over og under overfladen. Den særlige gel kan udskiftes og indeholder alle de næringstoffer, der er nødvendige for en plante at overleve i det lille økosystem.
Plantarium, 3 små beholdere
Super Plantarium, 1 stor beholder
Start dit plantarium op på ny!
Lav din egen miniregnskov i denne store beholder med meget få redskaber. Dit økosystem kan stå i lang tid som lukket kredsløb og fungerer som model på større økosystemer.
Tilsæt kul, lecakugler, fugtig jord, samt stiklinger, små planter, sten og mos. Fugt det hele godt og stil økosystemet lyst, men ikke direkte i solen.





Frø udsat for stråling, anvendes til at påvise virkningerne af varierende grader af stråling. Præparater af rodspidserne viser tydelige forstyrrelser af det normale mitotiske mønster. Somatiske ændringer anlagt ved bestråling er ofte tydelig kort tid efter spiring begynder.
Radisefrø
Majsfrø til genetiske forsøg med klorofylmutanter. På kun 2 uger ses resultater i planternes dominante og recessive gener. Leveres i breve med 100 frø.

Rapsfrø
Studer blomsters anatomi og opbygning.


Komplet lyssystem til mindre/større arealer, hvor designet giver en god lysspredning.. Perfekt til både undervisning, hobbygartnere og professionelle, som ønsker kvalitets plantelys til en lav pris. LED-pærer medfølger (50.000 timers levetid). IR- og UV-pærer kan tilkøbes.


Grøn/albino 3:1 Høj/dværg og grøn/albino 9:3:3:1

Vores serie af grotelte, lavet i 3 tilgængelige størrelser for at imødekomme alle behov for planteformering. Perfekt designet til at huse stiklinger, frøspirer, små planter mm.
Denne mindste model i serien er velegnet til start af frøplanter, eller stiklingeformering af alle slags planter.
Mellemstørrelsen med en ekstra højde er velegnet til både planteformering og -start, men også små moderplanter og lign. Kan etage inddeles ved hjælp af metalhylder (tilkøb).
Den største model er lavet til planteformering i større skala og kan konfigureres til at have op til 5 etager (hylder medfølger) og en kapacitet helt op til 1650 stiklinger eller frøplanter.



Perlerne skifter farve, når de udsættes for sollys (uv-stråling) og kan bruges igen og igen.
Kraftig nok til at gøre ædelstene og mineraler fluorescerenede selv i normal rumbelysning. Brug den også i forbindelse med forsøg med UV - perler.

Sæt fremstillet i plast. Det ene absorberer UV og det andet gør ikke.




Monitor
Udforsk strålingsdata, mål radioaktivt forfald og overvåg radonstråling.
Sensoren består af et Geiger-Muellerrør monteret på et lille, robust plastikhus og gør det muligt at spore alfa-, beta- og gammastråling. Brug monitoren i flere eksperimenter:
• Bestem halveringstiden for en isotop
• Undersøg strålingsafskærmning
• Opdag baggrundsstrålingskilder

Meget brugervenlig radonmåler som er udviklet til måling af radonniveauet i eks. bygninger. Sæt batterier i og vent til apparatet har udført den automatiske kalibrering - så er du klar.

Praktiske beskyttelsesbriller til en sikker UV-undervisning. Kan også anvendes til ravjagt.

Kombucha-tesvampen 'SCOBY' er den oplagte undervisningsmakker til tværfaglige forløb i biologi, kemi, bioteknologi m.fl.
SCOBY, der står for “symbiotic culture of bacteria and yeast”, er en blanding af gærceller og gode bakterier i en cellulosemasse.
Lær f.eks. om:
• cellebiologi: overordnet opbygning af pro- og eucaryote celler og membranprocesser
• mikrobiologi: vækst og vækstfaktorer
• makromolekyler: overordnet opbygning og biologisk funktion af carbohydrater, lipider, proteiner og DNA
• enzymer: opbygning, funktion og faktorer, der påvirker enzymaktiviteten
• biokemiske processer: fotosyntese, respiration og gæring
• økologi: samspil mellem arter og mellem arter og deres omgivende miljø
SCOBY
Minimumvægt 35-40 g inkl. lidt startervæske.
Et vigtigt og alsidigt redskab til både laboratorie og udeaktiviteter. Live-aflæsning og indsamling af data. pH-sensoren kan anvendes til forsøg med enzymer, hvor det er muligt at undersøge enzymaktiviteten ved varierende pH-værdier.

Flydevægt til at bestemme sukkerindhold i gærede væsker, som vin eller øl. Kan bruges til at fastslå, hvor langt i gæringsforløbet væsken er, og til at beregne alkoholprocenten.

Til bestemmelse af sukkerindholdet i fødevarer som f.eks. frugt, grøntsager, juice og drikkevarer, der indeholder sukker. Ligeledes er refraktometeret oplagt til måling af sukkerindholdet i mæsk ved alkoholproduktion.




Hurtig og effektiv indikator, til måling af glukosekoncentrationen i væsker. Pakke med 50 stk.

Cellerespiration og gæring, sæt
Sæt fokus på de fysiologiske forskelle mellem aerob cellulær respiration og gæring. Lær om ATP-produktion i glykolysen, citronsyrecyklus og elektrontransportkæden og sammenlign ATP-produktionen af både mælkesyre- og alkoholgæring. Inkl. materialer til 32 elever og vejledning (engelsk).
Lipase, 25 g
Hydrolyserer triacylglyceroler (fedtstoffer) i fedtsyrer og glycerol.
Pektinase, 100 mL
Enzymet nedbryder cellevægge og benyttes i juiceproduktion.
Pepsin, 25 g
Et vigtigt enzym i mavens fordøjelsessystem.
Laktase, 50 mL
Nedsætter indholdet af laktose i mælk.
Amyloglukosidase, 100 mL
AMG fjerner glukose fra flydende stivelse og producerer glukose.

Cellulase, 25 g
Cellulase er et enzym som spalter cellulose til glukose.
Katalase, 1 mL
Omdanner hydrogenperoxid til ilt og vand.
Osteløbe, 100 mL
Mikrobiel osteløbe.


Neutrase, 100 mL
Neutrase nedbryder proteiner til polypeptider eller peptider. Bruges f.eks. til at udvinde DNA fra løg.
Termamyl, 100 mL
Varmestabil a-amylase, bakteriel. Enzymet anvendes blandt andet i vaskemidler og opvaskemidler.
Osteri, lav din egen ost
Alt det du skal bruge - undtagen mælken - er med i dette ostekit. Fremstil en række spændende oste: hytteost, camembert/brietype, blåskimmelost/castellotype, fetaost, havarti og danbotype, ricotta, myseost, rygeost, friskost og flødeost.
Inkl. forbrugsstoffer til ca. 20 ostninger á 8 liter mælk (forbrugsstoffer kan løbende tilkøbes).

Kom nemt igang med at lave læbepomade af naturlige råvarer. Sættet indeholder råvarer til 10 stk. læbepomader: kakaosmør, bivoks, sheasmør, læbepomadehylstre og opskrift. Udover sættets indhold skal der bruges almindelige køkkenredskaber.
Brug sættet til forløb om tilsætningsstoffer.
Ekstra læbepomadehylstre

Til vin, olivenolie og juiceproduktion - italiensk kvalitetsmærke! En star-presse model er en rigtig arbejdshest og derfor særlig anvendelig til institutionsbrug.
Begge modeller kan også anvendes til hårdere frugter, som æbler og pærer.
Modellen rustfrit stål er særligt nem at rengøre (en særlig lukkemekanisme halverer kurven, når pulpen skal fjernes).
Materialevalget sikrer minimal vedligehold og alle metaldele er pulverlakeret. Pressepose medfølger.
20 liter, lakeret bøg
20 liter, rustfrit stål
Smørkærne 1,6 l
Til hurtig smørfremstilling er denne franske kærne særdeles effektiv. Glasbeholderens form i kombination med rotationen omdanner hurtigt den syrnede fløde til herligt smør og rigtig kærnemælk. Inddrag den i læren om laktose/laktase.

Pektinase, 100 ml
Enzymet nedbryder cellevægge og benyttes i juiceproduktion, for at optimere mængden af juice.

Laktose, ren 250g mælkesukker-

Laktase, 50 ml
Nedsætter indholdet af laktose i mælk.

I forbindelse med arvelære bruges ofte det illustrative Punnett Diagram (krydsningsskema). I diagrammet placeres den ene forælders forskellige alleler (de der muligt kan være tilstede i individets gameter) i to celler ved siden af hinanden og den anden forælders alleler i to celler under hinanden, hvorefter de nemt "krydses".
De 56 magnetiske blomster i dette sæt viser 3 typer monohybrid krydsninger (fuldstændig dominans, u-fuldstændig dominans og co-dominans). Sættet inkluderer lærervejledning (engelsk).

Nu får du en ekstra - nemlig 6 antropologiske kranier i vores populære sæt. Sættet består af Afarenis kranium, Africanus kraniumNY!, Habilis kranium, Erectus kranium, Neanderthalensis kranium og Steinheim kranium.
Hvert kranie måler cirka 25 cm. Håndmalede detaljer og realistiske teksturer gør disse replikaer til et fremragende værktøj til uddannelsesstudier.
Sættet fremstilles nu af holdbar og vaskbar plastisolpolymer, og vil denne replika modstå lang tids brug og håndtering. Brug dem til øvelser med evolutionslære og kraniemåling.
Arbejd med systematik, sortering og klassifikation på en aktiv måde.
Måler 160 x 160 cm.
Måler 120 x 120 cm.
Flere, bedre, billigere!
Spar hele 55% OG få et ekstra kranie med!





Detaljeret DNA-model der viser: dobbeltspiral-strukturen i DNA, fosfatdeoxyribose ”rygraden”, og de fire baser: adenin (A), guanin (G), thymin (T) og cytosin (C). De forskellige molekyler og bindingerne imellem vises realistisk og tydeligt. Illustrerer på en god måde baseparringsreglerne. Måler 61 cm.

- et kriminalteknisk
Komplet sæt til indsamling af fingeraftryk med politiets metode. Eleverne lærer ved hjælp af sættet at tage fingeraftryk, klassificere mønstertyper i aftrykkene og at identificere ukendte fingeraftryk og på den måde finde forbryderen blandt deres klassekammerater. Inkluderer udførlig dansk vejledning med teori og øvelsesbeskrivelse.
Magnetisk materiale til f.eks. whiteboard. Klip ud og arbejd med den interaktive model og udvikl derved modelleringskompetencer. Lav også stopmotion-film af processen.
Lær om den del af proteinsyntesen, der foregår ved cellens ribosomer (translation). Forklar processen og forklar sammenhænge mellem mRNA, ribosom, tRNA og aminosyrer.


Vis replikationen og lav et dobbeltstrenget DNAmolekyle ved at sætte A-T og G-C over for hinanden. I transkriptionen dannes mRNA-strengen ved at sætte A-U, T-A og G-C over for hinanden. Illustrer de to processer og forklar reglerne omkring baseparringsprincippet.




Eleverne går direkte ind i rollen som cytogenetikere, der arbejder på et hospital, mens de undersøger de diagnostiske muligheder i karyotype-undersøgelser. Alle materialer i sættet kan genbruges.
Materialet er beregnet til en klasse med 30 elever, der arbejder i par.
• Forstå anatomien af humane kromosomer
• Diagnosticer patienter vha. kromosomundersøgelser
• Få talt om elevernes misforståelser i forbindelse med kromosomer
• Genbrug sættets unikke kromosomundersøgelsestavler og mærkater

Komplet sæt til 30 tests inden for ABO og Rhesus systemerne. Med kort, lancetter, plastpinde og desinfektionsservietter. Dansk brugsanvisning indeholder lidt historie om blodgrupper, geografisk fordeling, samt forklaring til de enkelte grupper.
Undersøger den genetisk bestemte smagsrespons hos elever og deres familier i forhold til 3 forskellige kemikalier. Sættet indeholder rør med: PTC, natrium benzoate, thiourea og kontrol teststrimler. Hvert rør indeholder 100 teststrimler.
Derudover inkluderes lærervejledning og stamtavle/ arbejdsark til kopiering (engelsk).
Blodtypebestemmelsesæt til 30 personer - et uundværligt redskab inden for biologiundervisningen. Med sættet tester eleverne 4 syntetiske blodprøver for at bestemme deres ABO og Rh blodtype. Den simulerede agglutination er meget realistisk.
Sættet indeholder ikke noget blod, blodprodukter eller andet af biologisk oprindelse, så der er ingen fare for overførsel af sygdomme.


Er tiden knap, så anvend disse færdigstøbte petriskåle. Tag dem ud af køleskabet og de er klar til podning - slip for opvarmning, dosering, støbning mv. med risiko for kontaminering.
PCA i petriskåle
Til totalkim bestemmelse (plate count). Færdigstøbt i petriskåle Ø90 mm. Pakke med 20 stk., sterilt indpakket og klar til brug.
Kødpeptonagar, rulle
Til dyrkning af bakterier. Pølsen skæres i passende skiver med en steril kniv. Rækker til 18-25 petriskåle Ø90 mm.
Maltekstrakt agar i petriskåle
Til dyrking af svampe - færdigstøbt i petriskåle Ø90 mm. Pakke med 20 stk., sterilt indpakket og klar til brug.
Kødpepton i petriskåle
Til dyrking af bakterier - færdigstøbt i petriskåle Ø90 mm. Pakke med 10 stk., sterilt indpakket og klar til brug.
Kødpepton

Til dyrkning af bakterier. Opsmeltes i kogende vandbad eller mikroovn. Vejledning er påtrykt flasken. Steril, rækker til ca, 12 - 15 stk. petriskåle Ø90mm. 250 mL.

Maltekstraktagar
Til dyrkning af svampe. Opvarmes i kogende vandbad eller mikroovn.
Vejledning er påtrykt flasken. Rækker til 10-15 petriskåle Ø90 mm. 200 mL.

OBS: Al agar skal efter brug destrueres ved f.eks. afbrænding eller overhældning med klorin.
Den ene side til colibakterier, den anden til almen bakteriepåvisning. Bakterieantallet aflæses direkte ved sammenligning med billedtavle. Kan anvendes i ferskvand, brakvand og saltvand - eller ved trykning imod overflader. Inkl. 10 prøverør, billedtavle og dansk vejledning.

Hygicult
Fordele:
• NordVal og AOAC valideret.
• Indeholder neutralisering af desinfektionsmidler.
• Hygicults knækled letter prøvetagning.
• Dansk brugsvejledning.
• Nem aflæsning ved hjælp af kontrolkort.
• Kræver ingen laboratoriefaciliteter udover et varmeskabdog kan resultater tit aflæses efter 1-2 døgn ved 37 °C.
• Standardiseret areal.
Hygicult Y & F
Beregnet til detektion af gær og skimmelsvampe/ svampesporer.


Hygicult TPC
Beregnet til monitorering af den generelle hygiejnestatus, da den fremmer vækst af alle typer af bakterier samt gær og skimmelsvampe.
Prisbillig bærbar digital inkubator - ideel til mikrobiologiske forsøg, såsom dyrkning af dyppeplader til mikrobiologisk analyse. Med den lave pris og kompakte størrelse er den perfekt til analyser på uddannelsesinstitutioner og små laboratorier. Et stort 20 liters kammer kan opbevare kolber og flasker op til 2 liter. Inkl. 2 justerbare/aftagelige hylder. Digital temperaturkontrol eliminerer behovet for eksterne termometre og gentagen "finjustering" af en analog kontrolknap. Blæser sikrer optimal temperaturfordeling. Temperatur +5 °C to +60 °C. 3 års garanti.
Hygicult E
Beregnet til bestemmelse af enterobacteriaceae (colibakterier).


Trods sin størrelse har dette skelet alle anatomiske strukturer og detaljer. Selve skelettet måler 80 cm (94 cm med ophæng).
Kraniet kan fjernes og adskilles i 3 dele. 3-delt aftageligt kranium (hovedskal, bund af kraniet, underkæbe).
• Aftagelige arme og ben
• Specielt monteret hofteled, til at demonstrere den naturlige rotation af hofterne
• Fleksibel ryg med bløde intervertebrale skiver.
Lavet af slidstærkt, brudsikkert plast med fuld 3-års garanti.


Populær torso med aftagelige dele og organer: blotlagt hjerne (ikke udtagelig) og kraniehalvdel, øje med synsnerve, 2 lunger, hjerte i 2 halvdele, mavesæk, lever, tarmsystem med dæksel til blindtarmen, forreste halvdel af nyre, samt forreste halvdel af urinblæren.
Mål: H87 x B38 x D25 cm.
Fin budgetvenlig torso i halv størrelse med detaljer af de anatomiske strukturer. Hjerne og indre organer kan tages ud og studeres nærmere. Venstre halvdel af torsoen viser muskulaturen og rygsøjlen er blotlagt.

Praktisk kranie i naturlig størrelse til demonstration, quiz og eksamen. Anvend kraniet på traditionel vis eller brug den unikke mulighed for at optegne strukturer eller lave notater med en alm. whiteboard tusch (ikke inkl.) og viske dem af igen. Toppen af kraniet og kæben kan tages af.



Overdimensioneret puslespil hjælper elever med at lære navne, form og placering af alle de store knogler i menneskekroppen. Hvert af de 15 stykker er navngivet på bagsiden (på latin og engelsk). Skelettet måler 122 cm, når det er samlet.

Denne model af en menneskelig nyre i næsten naturlig størrelse viser nyrebækkenet, renal medulla, nyrebægeret, nyrebarken, nyrearterien og venen, urinlederen og binyrerne i håndmalede detaljer.


Den forreste hjertevæg kan fjernes for at vise de indre strukturer i detaljer. Alle vigtige strukturer er til stede, såsom ventrikler, atrier, aorta-, mitral-, lunge- og tricuspidventiler. Hjertemuskel, fedtvæv, arterier og vener er malet i detaljer.


Flot hjernemodel i 1:1, der viser hjernens essentielle anatomi i realistiske farver.
Modellen passer ind i flere kraniemodeller, eks. SCER 4500 og SCER 4505.


Model i 1:1, der viser de vigtigste anatomiske vartegn og kortikale områder i hjernen. Højre halvdel viser vise hjernens fire lapper: parietal, tidsmæssig, occipital og frontal. Venstre halvdel er opdelt i fire dele - frontale/laterale lapper, de tidlige og occipitale lobes samt hjernestammen og cerebellum. Hjernen er malet således, at hjernens 5 cerebrale cortexområder kan ses. Modellen passer ind i flere kraniemodeller, eks. SCER 4500 og SCER 4505





Model med hjertekamre, hovedpulsåre, vener og lunger, som med en håndpumpe demonstrerer blodgennemstrømningen i hjerte og lunge. Ingen oprydning da væsken er indkapslet.
Skummodel af hjerne, hjerte, øje eller tand, som hjælper eleverne til at forstå anatomiens kompleksitet.
Modellerne deles i to med hhv. navnene på vigtige områder (på engelsk) og påtrykte numre på den anden. Engelsk vejledning medfølger.
Hjerte
Varenr.: 231071
Tand UDGÅR!
Varenr.: 231070

Hjertet (fra en gris, en ko eller et får) placeres midt på dugen, så anvisningerne kan følges i forbindelse med undersøgelsen.Efter endt undersøgelse rengøres dugen med en mild sæbeopløsning. Når dugen er tør, kan den lægges væk og er klar til næste gang, der skal dissekeres et hjerte.

Øje, tværsnit
Varenr.: 231072
Hjerne
Varenr.: 100073
Dobbelt så meget læring med skelettet på den ene side og organer og muskelgrupper på den anden. I alt 17 magnetiske felter, 91 cm høj.



UDGÅR
BEGRÆNSET LAGER!




Budgetvenlig model,gengivelse af alle anatomiske detaljer viser den auditive kanal, trommehinden, hammeren, ambolten, stigbøjlen og sneglen. De omkringliggende knoglestrukturer, samt muskulære og bruskvæv er synlige.


Kompleks, håndmalet reproduktion af et menneskeøje i cirka 4x naturlig størrelse. Inkluderer to halvdele af sclera med nethinde og øjenmuskelfæstninger samt glaslegeme, linse, hornhinde og iris - i alt 6 dele.

Undersøg flere af de fysiologiske processer, der er involveret i menneskets synsopfattelse. Med udstyret kan eleverne undersøge synets skarphed, dybdeperception, farvesyn, bygningsfejl, positive og negative efterbilleder, optiske illusioner, m.m. Inkl. materialer til ca. 30 elever, der arbejder i små grupper.


Lav ti stationer, hvor eleverne undersøger egen hørelse og lærer om fysiologi og fysik bag lyd. Lav forsøg med: retningsbestemmelse, knogleledning og høretest. Viser sammenhængen mellem: lydbølger, tonehøjde og lydstyrke, om ørets opbygning, hvordan enkelte dele bidrager til hørelsen, og hvorfor høje lyde giver nedsat hørelse. Inkl.materialer til 30 elever i grupper af 3 (engelsk vejledning).



Stor model i 7 dele, der viser synsnerven og øjets position i øjenhulen.. Øjeæblet kan tages ud og adskilles i:
• begge halvdele af senehinden med hornhinden og øjets muskelvedhæftninger
• begge halvdele af årehinden med iris og nethinde
• øjets linse
• glasøje

Populære promillebriller fra Drunk Buster til simulering af nedsat reaktions- og koordineringsevne, dobbeltsyn og forvirring. Designet som skibriller, der sidder stabilt ved bevægelse.
Vælg mellem 5 forskellige styrker:
0-4-0,6 - 0,6-0,8 - 0,8-1,5 - 1,5-2,5 - 2,6-3,5

Cannabis/hashbrille

Bruges til måling af lungernes vitalkapacitet.
Spirometeret måler den gennemstrømmende luft, som aflæses på en skala inddelt fra 1000 til 7000 ccm. Spirometeret er kun 15 cm højt. 50 mundstykker medfølger.

1/100 sek. (ikke illustreret)
Mundstykker, 50 stk.

Til måling af lungernes vitalkapacitet. Undersøg hvordan forholdet mellem højde og alder påvirker lungekapaciteten. Sættet består af 4 poser og tilhørende mundstykker.
1/5 sek. (ikke illustreret)
1/1 sek.




Med Turi E80 Endurance motionscykel kan du træne som en professionel. Cyklen tilbyder dig helt op til 43 forskellige træningsprogrammer indbygget i computeren. Den er også kompatibel med træningsapps (eks. Kinomaps, Tunturi Routes) for mange flere ruter og programmer. Motionscyklen kan bruges af langt de fleste og er perfekt til genoptræning, da den har en meget lav indstigning foran.
Computerdata med:
• hastighed
• kalorier
• puls
• distance
• træningstid
• programmer


Til pædagogisk anskuelse af beregning af konditionstal.

Den stabile TOUR 400 garanterer begyndere moderne, effektiv træning med absolut glathed og maksimal komfort. Enkle justeringsmuligheder for sadel og styr sikrer en behagelig pasform, selv ved lange sessioner. Inkl. 10 træningsprogrammer og computerdata med:
• hastighed
• kalorier
• puls
• omdrejningstal
• distance
• træningstid
• watt

En af de mest anvendte metoder til bestemmelse af den maksimale iltoptagelse er Douglas-sæk-metoden. Det er ud fra denne metode muligt at bestemme den maksimale iltoptagelse med stor nøjagtighed.
Sækken anvendes til opsamling af ekspirationsluften med henblik på undersøgelse af respiration, stofskifte og minutvolumen. Komplet med slange (2 m), mundstykke, næseklemme, ensretterventil og omskifter.



I samarbejde med danske gymnasielærere har vi udviklet en række spændende øvelser til undervisning i diverse geologiske kerneområder. Stensamlingerne kommer med komplette vejledninger tilpasset de danske grundskoler og studier.
Det geologiske kredsløb
Æske med 11 tyndslib, der kan bruges separat eller sammen med bestemmelsesdugen "Det Geologiske Kredsløb".
Indeholder: basalt, granit, gabbro, gnejs, kvarts, sandsten, biogen kalksten, flint, syenit porfyr, carbosilikat skifer og konglomerat.

Praktisk æske med 3 tyndslib; skifer, sandsten og biogen kalksten til undervisning i dannelsen af olie/naturgas, samt lagring af CO2 i undergrunden.


til mikroskop
Universal adapter, der kan anvendes alle smartphones til bino- og monukular mikroskoper. Nemt og enkelt uden værktøj eller software.




Flot og detaljeret danmarkskort printet på en kraftig plastdug, som den kendes fra vore bestemmelsesduge. Dugen holder til at man går eller sidder på den, og kan derfor lægges ud på gulvet eller tages med på ekskursion. Der kan også tegnes på dugen med farvekridt og dugen tørres nemt ren med en fugtig klud. Ofte kan det være hensigtsmæssigt at have kortet fremme i undervisningslokalet over en længere periodehæng derfor blot dugen op med magneter på whiteboard eller opslagstavle. Måler 137 x 155 cm.
Håndtaget kan justeres i fire forskellige indstillinger og passe til både børn og voksne. Hjulet er belagt med gummi og kan anvendes inde og ude

Handy lille elektroniske måler informerer om afstand og forventet ankomsttidspunkt mellem to punkter meget præcist. Indtast kun kortets målestok og du vil med det samme kunne måle afstanden på kortet. Robust og vejrbestandig.



"Kør ruten" på landkortet og aflæs afstanden i kilometer direkte på én af 8 skalaer med forskellige målestokforhold.
Kan måle på følgende kort: 1:500.000, 1:300.000, 1:200.000, 1:150.000, 1:100.000, 1:75.000, 1:50.000, 1:25.000.



Meget solid med teleskopben, der kan højdejusteres. Højdeindikator med bevægelig vandret og lodret indstilling med tydelig afmærkning i grader.
Populær hvid globus med konturer af kontinenter, overordnede landegrænser og større floder. Tegn havstrømme, quiz hinanden om landenavne og meget mere!
Inkl. 4 "dry wipe" tuscher.



Flot og stor kvalitetsglobus på metalstativ med hjul - perfekt til faglokalet.
Dobbeltfunktion med fysisk/politisk kort, når den er slukket/oplyst. Ø50 cm, 103 cm høj.
Med dansk tekst, plastfod, lys og flotte illustrationer af dyr og vartegn! Ø30 cm.




Globus med indbygget stangmagnet til at simulere jordens magnetfelt, således at man kan undersøge det med f.eks. en magna probe eller et kompas.




Pusleglobus
Det er aldrig for tidligt at lære om geografi - og det kan være nemt og sjovt! Hvert kontinent er flytbart, men passer kun et sted. Flot illustreret med sjove dyr og berømte vartegn.

Flot globus med lys og 3D-relief over landområderne, så bjergkæderne fremhæves. Når globussen er tændt er den politisk og i slukket tilstand er den fysisk. Måler 30 cm, monteret på sort plastfod og med engelsk tekst.
De traditionelle globusser i deluxe eller basismodel. Begge har en dobbeltfunktion, der viser den fysiske information, når den er slukket, hvor ørken, skov og hav fremtræder i klare farver. Når lyset er tændt, gennemlyses et underliggende lag, der viser tydelige politiske inddelinger og landegrænser fremtræder tydeligere. Diameter 30 cm.
Globus deluxe med bøgetræsfod og meridian i messing
Basisglobus med sort plastfod (ikke illustreret)



Grundvandsmodel
Betagende grundvandsmodel beregnet til at give en visuel demonstration af basale grundvandsprincipper eller i forbindelse med hydrogeologiske forsøg.
Begreber som porøsitet og permeabilitet, grundvandsstrømmen, karakteristika for akvatiske stoffer, dannelse af en kegle af depression, brøndkontaminering, overfladeudvaskning af forurenende stoffer og mere, bringes til live. Tilføj farvestof til at vise grundvandsstrømningslinjer, virkningerne af pumpning af brønde og virkningen af kontaminering på ferskvandsforsyninger. Inkl. danske øvelsesvejledninger med;
• den teoretiske baggrund
• formålet med øvelsen
• vejledning i udførsel af øvelsen
• opsamlende arbejdsspørgsmål
• lærerdel med tidsforbrug og forberedelse
• oversigt over de FFM/dele af bekendtgørelsen
øvelsen opfylder
Grundvandsmodel Sediment-refill



Vælg mellem hæmatit, kobber, magnetit eller bauxit.
Bauxit (10 stk.)
Magnetit (10 stk)
Hæmatit 10 stk.
Kobber (10 stk..)
Basalt (8 stk.)

Med dette mineralsæt (15 stk.) kan man nærstudere mineralernes påvirkning af ultraviolette stråler - både de langbølgede og de kortbølgede.





Sigtesæt til bestemmelse af kornstørrelsen. Dette sæt er tilstrækkeligt til klassificere kornstørrelse og jordtyper, som f.eks. ler, sand, silt og grus. Kanterne er lavet i plastik og har en diameter på 170 mm. Sigtebundene er lavet af messing eller rustfrit stål.
3,35 / 1,7 / 0,25 / 0,071 mm.
3,35 / 1,7 / 0,43 / 0,25 / 0,125 / 0,071 mm.


Vælg mellem 5 fantastiske samlinger - eller køb dem alle og spar penge! Vælg mellem: metamorfe, sedimentære eller magmatiske bjergarter, fossiler eller mineraler.

Udarbejdet til øvelsesvejledningen "Navngivning af Magmatiske Stenarter".
Indeholder:
Granodiorit
Dolerit
Basalt
Gabbro
Pink Granit
Rhyolit
Andesit
Diorit



Test hårdheden med Moh's hårdhedsskala med glaspladen, sømmet og kobber kvadratet. Undersøg stregfarven med stregpladen og se hvorvidt mineralet har stærke, mellem eller svage magnetiske egenskaber. Test opbrusningen med dråbeflasken og saltsyre (ikke inkl.!) og brug foldeluppen til nærstudier.

Udarbejdet til øvelses-vejledningen "Pladetektonik og Densiteten af karakteristiske bjergarter".
Indhold:
Granit
Basalt
Peridotit
Eklogit



- den interaktive sandkasse!
• Få mediedidaktik, innovation og modellering ind i undervisningen
• Brug iSandBOX i naturfagene, sprog- og kulturfag, sanse-terapi m.fl.
• Styrk skolens teknologiske profil


'One tool to rule them all'
- så meget læring i ét læringsværktøj!
Dette revolutionerende læringsværktøj er taget i brug i gymnasier, grundskoler og skoletjenester landet over, hvor undervisere melder tilbage om spændende læringsforløb i geografi og biologi indenfor bl.a.:
✅ Hotspotvulkaner
✅ Caldera
✅ Koralrev & atoller
✅ Erosion
✅ Vandets kredsløb
✅ Topografisk opland

✅ Regnvejrstyper
✅ Klimaforandringer
✅ Fluvialmorfologi
✅ Istidslandskaber
✅ Høje vs. lave gletchere
✅ Artsdannelse
✅ Klimazoner
✅ Plantebælter
✅ Kartografi
✅ Planeter
✅ og meget mere!

Form jeres lokalområde i sand! Scenariet har justerbar målestok og konturlinjer gør det nemt at lave en præcis gengivelse af et terræn med vandveje, bakkedrag og lavland.

Bestil en 'playdate' i sandkassen, hvor vi kan demonstrere og I selv kan prøve iSandBOX' 29 spændende scenarier. Vi arrangerer gerne demonstrationer på forskellige lokationer rundt om i landet eller laver fremvisninger via Zoom eller lign.
Kontakt os på tlf. 4913 9333 eller info@scandidact.dk.




Vandets kredsløb
Skip tavleundervisning og demonstrer vandets kredsløb, vejrsystemer og de forskellige regnvejrstyper - det er rent magi, når I lader det regne i sandkassen med jeres egne hænder!

Lær om vulkaner og deres funktioner, årsager, samt påvirkning af miljø og mennesker. Modellen illustrerer de forskellige skorper, lavarør og dannelse af vulkanen, samt tværsnit gennem vulkanen.
Mål: 42 cm lang x 42 cm bred, 21 cm høj.
Lang bølgespiral til at demonstrere og observere jordskælvsbølger. Fjederen måler 20 cm komprimeret og kan strækkes op til 20 meter. Opbevares på det medfølgende træstativ, hvilket forlænger levetiden betragteligt.

Undersøg vulkanske, sedimentære og metamorfe bjergarter, der nedbrydes og gendannes i et evigt geologisk kredsløb.
Flot model, der viser dannelsen af ny havbund ved en undersøisk vulkan. Modellen viser eks. kontinentalsokkel, forkastninger, foldebjerge og dybgravsdannelse.

Seismograf Model til demonstration af seismiske forstyrrelser i faglokalet. Kan bruges til både matematiske og geologiske koncepter. Træk langsomt i papiret og start "optagelsen" af bevægelser i nærheden af modellen - eks. ved hop på gulvet eller bank i bordet.


Vis forkastninger og folder i jordskorpen, effekten af tektonisk stress m.m. Inkl. identifikationsnøgle.


Otte separate modeller danner en 3D-model med bjerge, søer, floder, ørkener, gletsjere, kystlinjer, kløfter og kulturelle punkter. Nu udført i håndmalet træ med filtunderside.

Til undervisning på eks. magnetisk tavle eller whiteboard.
Basis (6 brikker á 20x20cm)
Til de yngste klassetrin i Natur & Teknologi med fokus på en enkel og konkret beskrivelse af vandets kredsløb. Nogle af brikkerne kan anvendes til basale meteorologiske fænomener.
Udvidet (16 brikker á 15x15cm)
Til de ældre klasser med N/T, udskolingen og gymnasiet med mere komplicerede modeller af vandets kredsløb. Sæt også fokus på problemstillinger i relation til udnyttelse af naturens ressourcer, vandbeskyttelse eller udfordringer med drikkevandsforsyning.


Lær om havbunden, havstrømme og pladetektonik. Modellen kan bruges, som den er eller nedsænkes i et fyldt akvarie (tilkøb) for en ekstra god læringsoplevelse. Under vand kan modellen f.eks. simulere havstrømme med lidt frugtfarve og lave undersøiske vulkanudbrud ved brug af en luftpumpe (ikke inkl.).



Boks fyldt med vedvarende energi, der giver en komplet forståelse af, hvordan brændselscelle-teknologi interagerer med vedvarende energikilder for at skabe et helt bæredygtigt elnet. Solenergi, vindenergi, kinetisk energi fra et håndsving og en demonstration af en superkondensators utrolige lagringspotentiale. PEM-brændselscelle, saltvandsbrændselscellen og en direkte ethanolbrændselscelle kan sammenlignes. Du skal bruge en brintkilde som Hydrofill Pro for at oplade den medfølgende Hydrostik Pro-patron med brint. Inkl. dansk øvelsesvejledning (fysik/kemi 7.-9. klasse og fysik C, B, A og geovidenskab A), samt praktisk opbevaringskasse med låg og hjul.
Kernestof i kemi: biobrændsel, elektrolyse, elektrokemi, ethanol reaktion, organisk kemi, pH, hydrogengenerering, reaktionshastigheder, halvledere, opløsningskoncentration

Kernestof i fysik: vinkelhastighed, kondensatorer, elektrisk ladning, lys, varme, klassisk mekanik, effektivitet, energi, elkraft, Ohm's Lov, elektricitet, rotationsmekanik, termisk energi, paralelle kredsløb, seriekredsløb
Kernestof i biologi/geografi: vedvarende energi, klimaforandringer, menneskets påvirkning


Sættet giver jer mulighed for at opfinde jeres egne applikationer med ren og vedvarende energi ved hjælp af brændselsceller og brint skabt ved hjælp af solenergi og vand.
• Udforsk serier og parallelle kredsløb og andre fysiskekoncepter med vedvarende energikraft fra en brændselscelle og et solpanel.
• Brug Solens kraft til at opdele vand og generere brintgas, mens du lærer om kemikoncepter.
Kernestof i kemi: elektrolyse, energi, hydrogengenerering, reaktionshastigheder, redoxreaktion, halvledere, støkiometri
Kernestof i fysik: elektriske kredsløb, energi, lys, elkraft, parallelle kredsløb, seriekredsløb, Ohm's Lov, elektricitet
Kernestof i naturfag: vedvarende energi

Slip innovation løs med den hurtigste brintbil i skala 1:20 i verden.
Vores H2GP Sprint brintbilssæt indeholder alt, hvad eleverne har brug for for at skabe deres egen brint, før de bruger det til at drive deres lynhurtige SPRINT brintbil. Når eleverne har stiftet bekendtskab med teknologien, skal de opmuntres til at skabe og bygge deres egen bil fra bunden og derefter bruge brændstofcellen og motoren til at drive den.
Eleverne samler H2GP Sprint brintbilen selv, hvilket giver dem mulighed for at forstå, hvilken rolle hver komponent spiller.

Endelig er det tid til at køre! Studerende vil naturligvis gerne køre mod hinanden, men det innovative SPRINT Curriculum giver en struktur, der kombinerer væddeløb med yderligere læring.
Nu hvor eleverne har alle værktøjerne til at ændre deres brintdrevne bil, er de frie til at følge deres fantasi og lave den hurtigst mulige bil. Dette omfatter redesign af bilchassiset ved hjælp af Computer-Aided Design (CAD) eller fremstilling af deres eget unikke bilkarosseri.

H2GP Sprint Brintbil kit
H2GP Sprint Brintbil klassesæt
H2GP Sprint kørebane
Den lette 10 meter lange træningsbane giver dig mulighed for at køre dine H2GP SPRINT brintbiler bogstaveligt talt hvorsomhelst – i gymnastiksalen, klasseværelsets bordplader eller nede på gangen.
Vandstrømsbord,
Lav den mest detaljerede og grundige demonstration af sedimentering og landskabsdannelse med vand. Størrelsen alene gør det muligt at lave store, flotte demonstrationer. Demonstrer dannelsen og forandringer af kystlinjen. Lad regnen skabe landskabet, følg vandløbet og sedimenteringen, aftegn topografiske konturer m.m.
- Hvordan udvikler et vandløb sig?
- Hvordan foregår erosion og aflejringer?
- Hvad er et dige?
Sættet inkluderer:
• Sort vandløbskar: 170 x 66 x 16 cm
• To individuelle vandløb, der flyder fra kontrolpanelet
• Bord støbt i kraftigt, brudsikkert plast på hjul
• Gitter til aftegning af konturer

Vandstrømsmodel
Demonstrer et vandløbs tilblivelse med erosion og aflejringer eller brug karret som tsunami-kar.
Karret måler 122 x 37 x 6,5 cm.
Kvartssand
Cirkulationspumpe

Designet som et udsnit af et naturligt landskab med højdekurver og farveforskelle. Landskabet har både bakker, dale, højdedrag, kildeudsping, snoede vandløb m.m. Landskabet kan skilles ad og bygges op. Inkl. identifikationskort, som hjælper til at lære at læse og forstå modellen og dens opbygning. Modellen måler 50 cm.

Ryst røret og observer den gradvise sedimentering, deponering og lagdeling, som den forekommer i floder, vandløb, sumpe, søer og hav.
Varenr.: 421631
Pris: 219,00 kr.




Vejrstation som blandt andet fungerer sammen med vejrtjenester, som f.eks. Wunderground, hvor du kan dele dine vejrdata med alle andre brugere.
Vejrstationen har en masse unikke funktioner heriblandt, inden- og udendørs temperatur og fugtighed, vindhastighed, vindmåler, regnmåler, UV-indeks, lufttryk, lysmåler, udendørssensor og meget mere. Stationen kan nemt monteres enten på væggen eller stå frit.


Lær eleverne, hvordan man nemt og enkelt kan filtrere urent vand til rent ved hjælp af naturlige materialer. Sættet viser nemt, hvorfor mange hurtigt løbende vandløb indeholder rent vand, samt den videnskabelige måde at udvinde salt fra havvand.


Vores udvalg af danskproducerede brætspil kan justeres i spilletid og er derfor perfekte til juleafslutning, vikartimer m.m.
Spil om miljø, grøn disponering og bæredygtighed.



3-i-1 kortspil for de mindste; Vendespil, Skraldeper og det sjove Fire på Phaunie.

Lad dyrene dyste mod i hinanden på en ny måde i det klassiske spil 'krig'.



Allerede i 1787 formåede Ernst Chladni at tegne symmetriske mønstre i sand kun ved hjælp af lyd. Hvis man sætter en metalplade dækket med sand i svingninger ved hjælp af lyd ved bestemte frekvenser, dukker de mystiske mønstre frem. Fænomenet kaldes ‘fundamentale vibrationsformer’
Nu kan I også "give lyden en form" og udføre eksperimentet, der stadig forundrer forskere og studerende i dag.
Elektromagnetisk vibrator til frembringelse af mekaniske bølger i f.eks. fjedre, gummibånd eller Chladniplader.
let at lære om elektronik - uden brug af værktøj!

Scandidact har et stort udvalg af sæt, der kan kombineres og med hvert sæt er der nok til mange timers læring og sjov.
Lær om basal kodning. Download Snap Circuits® app'en og brug din smartphone/tablet og Snap Circuits® kodningsmodul til at styre dine projekter med lyd, lys og bevægelige dele. Fra 8+.

Lær om moderne vedvarende energiformer - udforsk elbiler, vindmøller og dynamo. Perfekt til den lille ingeniør! Fra 8+.
• Udforsk ren energikoncepter, såsom elbiler, vindmøller og håndgenereret strøm.
• Lær det grundlæggende i elektronik og moderne alternativ energi!
• Hjælp miljøet og hav det sjovt med at lære om alternativ strøm, energibesparelse og hvordan elektriciteten i din verden fungerer




Cykelhjul monteret med håndtag på hver side af rotationsaksen. Kan bruges til demonstration af gyroeffekt og impulsmoment.
Kan monteres med en snor, så det hænger frit.
Kraftmåleren måler kræfter fra trin, hop og andre handlinger i menneskelig skala og anvendes bl.a. til påvisning af Newtons tredje lov. Platformen er omtrent samme størrelse som en normal badevægt og med to måleområder.
Kablet med LabQuest 2/3, PC eller LabQuest Mini
Trådløs via bluetooth til gratis app eller med USB-stik til LabQuest 2/3 eller PC.
LabQuest 3 med touch screen og WiFi/Bluetooth er en af de bedste og mest brugervenlige dataloggere til undervisningsbrug på alle niveauer nogensinde.
Benyttes til forsøg indenfor dynamik, hvor der skal undersøges omdannelse af potentiel energi til kinetisk energi.

Apparat til forevisning af kraftmoment. På metermålestokken kan de medfølgende vægtlodder (100 og 200g) placeres til forevisning af kraftmoment. Både målestok og lodder kan flyttes.




LabQuest Mini er løsningen, hvis der ikke behøves et håndholdt apparat med ”touch screen”, og dataopsamleren i stedet ønskes koblet direkte til en Windows eller Mac.


Apparat til forevisning af det hydrostatiske paradoks; at bundtrykket i et kammer med væske afhænger af afstanden til overfladen alene og ikke af kammerets udforming.

månens kredsløb
Demonstrerer dagslys, nat, årstider og månefaser. En 12 V pære i solen hjælper til at demonstrere sollys på månen og jorden. Basen viser årets måneder og sæsoner. 33 cm høj. Bruger to AA-batterier (medfølger ikke).



Flot sæt i messing og træ - til demonstration i thermal udvidelse. Kuglen vil gå igennem ringen, når den er kold,

af hver metalstang og observer stearinen smelter i forskellige tempi.

konstellationer
Flot stjerneglobus på fod med 8cm jordklode i midten. Viser mælkevejen, samt de store stjerner og stjernebilleder. Ø30 cm.


Acetylsalicylsyre, ren, 250g
Fosfat, standardopløsning 500 mL
Natriumchlorid, fint, 200 g
Ammonium jern(III)nitrat, 100 g
Hex-1-en, 500 mL
Natriumhydroxid, granulat, 200 g
Bariumnitrat til analyse, 250 g
Kaliumbromid, ren, 100 g
Natriumiodid, ren, 100 g
Calciumchlorid, 0,01 M
Kaliumdihydrogenphosphat, 250g
Natriumthiosulfat, 1 kg
Calciumhydroxid, melfint - 1kg
Kaliumferricyanid, 250 g
Octanol-1, ren, 100 mL
Calciumoxid, pulver, 500 g
Kaliumiodat, ren, 100 g
Phosphatase, 1KU, 500 ml
Cetylalkohol, 100 g
Kaliumiodid, ren, 100 g
Salicylsyre, ren 500 g
Eddikesyre, min 99 %, 1 L
Kobber(II)sulfat, ren, 200 g
Thiocarbamid, 500g
Ethanol, 99,9 %, udenatureret, 1 L
Natriumacetat, vandfri, 500 g
Æter, 500 mL
KØB JERES KEMIKALIER HOS SCANDIDACT HER ER ET LILLE UDVALG (kontakt os gerne... vi

Arbejd med et molekylebyggesæt, hvor alle kan være med. Elementerne klippes ud og materialet er magnetisk, så det f.eks. kan anvendes på et whiteboard.
Det periodiske system i en magnetisk udgave, så det f.eks. kan anvendes på et whiteboard. Alternativt fås samme model i en praktisk plastdug i samme holdbare kvalitet, som I kender den fra de populære bestemmelsesduge. Dugen kan holde til at man går eller sidder på den, og den kan derfor med fordel lægges ud på gulvet. Man kan også hænge den op på en opslagstavle.
Plastdug Magnetisk dug


Kemiskabets must-haves:
Agarpulver, PCA, 190 g

Fehlingsvæske I, 1 liter
Pimpsten, kogesten, 200 g
Præparatfarve, eukitt
PH 4,0 Kalibreringsopl. PH-Analyse
Præparatfarve, hämatoxylin 'Hansen'
Fehlingsvæske II, 1 liter
Glukose, druesukker 500g
Magnesiastænger, 25 stk
PH 7,0 Kalibreringsopl. PH-Analyse
Præparatfarve, bromthymolblåt 0,04%

Nitrat og nitrit teststrips
Pepton, ren, 100 g
Præparatfarve, carmin i eddikesyre 0,5%
Præparatfarve, jod-jodkalium 'Gram'
Præparatfarve, lysgrøn safranin
Præparatfarve, methylénblåt 1%
Præparatfarve, eosin 1%
Præparatfarve, methylviolet 1%

Robust og pålidelig lommeformat tester med hurtige og præcise aflæsninger. Er udstyret med en amperometrisk grafitelektrode, der giver en bedre repeterbarhed, da de ikke oxiderer. Kalibreres med medfølgende værktøj.


Refraktometer til simpel og analog måling af saltindhold i vand. Kan f.eks. bruges til at bestemme saliniteten i havvand. Måleområde fra 0 til 28 %.

De tyskproducerede mikropipetter giver med deres afrundede form og soft grip-gummibelægning en behagelig og sikker håndtering.
• Ergonomisk udført for behagelig håndtering
• Maksimal præcision og nøjagtighed
• Farvekodede
• Nem og hurtig kalibrering og vedligeholdelse
• Autoklaverbare
Vælg mellem: 0,1 - 2,5µl, 0,5 - 10µl, 2 - 20µl, 10 - 100µl, 20 - 200µl, 100 - 1000µl, 500 - 1000µl
Model UN30. Regulering af temperatur fra +30o til +220o C. Temperatursikring, tænd-slukur med digital aflæsning i 1/1o Leveres med 1 stk. trådhylde i rustfrit stål.


Digitalt vandbad med 6 huller med låg. Ikkefuget vandtank udført i korrosionsbestandigt rustfrit stål. Den ydre skal er fremstillet med en slidstærk pulverlakering, der er kemikalieresistent.
Karret måler 500 x 300 x 150 mm.

Få styr på kemikalieskabet med mærkning og korrekt sikkerhedsskiltning.
Vore labels er resistente overfor kemikalier og tåler nitrogen, nedfrysning, vandbad og autoklaveringperfekte til kemilokalet.
Køb en handy håndholdt labelprinter i dag og få orden i sagerne.
Laboratorieprinter, startpakke
Alt du skal bruge for at kunne mærke kemikaler og andet materiel i laboratoriet med tekst og advarselssymboler. Printeren tåler stød og fald. Design, skab og udskriv via et intuitivt tastatur og ved hjælp af forskellige symbolkategorier i menuen. Genbrug og tilpas labels, der er gemt lokalt på printeren, og opret fra bunden med indbyggede guider til labeldesign. Labels sidder fast og bliver siddende på overflader, og de kan modstå kulde, varme, fugt, vejrforhold og meget mere. Der fås ark med tekniske data til alle materialer.


Stødsikker op til 1,8 meter. Gem data filer på USB drev eller del label-filer mellem forskellige printere. Kan tilsluttes PC via USB eller op til 5 smartphone-enheder via app'en "Express Label App". Printer i sort/hvid.


Multianvendelig, permanent labeltape i vinyl, der er både varme-/kulde-, samt kemikalieresistent.



CE godkendt efter EN166 og EN170. Kan benyttes af brillebrugere og har sidelinse med udluftning, 180° synsfelt
Linser i slagfast polycarbonat, 100 % UV-beskyttelse (op til 380 nm).

Endelig også til børn: laboratoriekitler til børnehave eller grundskole i 100% bomuld med brystlomme, 2 sidelommer og knaplukning. Fås i mange størrelser.

Bægerglas, lav form, 10 stk. (fås også som 1 stk.)
Bægerglas, høj form, 10 stk. (fås også som 1 stk.)
Erlenmeyer kolber, 10 stk. (fås også som 1 stk.
Treben
Trefod i stål med zinkbelagt overflade.
Dobbeltmuffe
Stativmuffe, der kan bruges både horisontalt og vertikalt.
Spatelsæt med 6 forskellige spatler og mikroskeer, samt en pincet.
Alt udført i holdbart, rustfrit stål.

Hvid laboratoriekittel i god, kraftig bomuldskvalitet, med trykknaplukning, brystlomme og 2 sidelommer.
Størrelserne fåes i: S-M-L-XL.


Minicentrifuge


Magnetomrører u/ varme
Magnetomrører m/varme, max. 10 liter


Vortex mixer - variabel hastighed
Engangsartikel, der smides væk efter brug - man kan dog afspritte skærmen til genanvendelse. Ansigtsskærmen kan bæres sammen med beskyttelsesbriller og alm. briller. Kan justeres til både børn og voksne. Ansigtsskærmen er gennemsigtig og synsvinklen er meget bred. Oplagt til brug i uddannelsesinstitutioner, i laboratoriet m.m..



Lavet af silikonegummi og temperaturbestandigt fra -50 °C til 250 °C. God beskyttelse mod varme og kolde overflader.

Se tekniske detaljer og vores fulde program af vægte på scandidact.dk/naturfag
En kompakt transportabel vægt, som er velegnet til en bred vifte af anvendelser. Med sin kompakte størrelse er den nem at finde plads til. Klar og tydelig aflæsning af resultater på LCD-display . Rustfri stålplatform, der er aftagelig for nem rengøring. Måleenheder: gram, ounces og pund. Netledning kan tilkøbes (varenr. CB 100).
Kapacitet: 500 g
Vejeinterval: 1 g
Nøjagtighed 0,1 g
Kapacitet: 500 g
Vejeinterval: 0,1 g
Nøjagtighed 0,1 g
Kapacitet: 1 kg
Vejeinterval: 0,1 g
Nøjagtighed 0,1 g
Core - serien en er det rigtige valg, hvis du værdsætter enkel betjening og ”værdi for pengene”. Vægten er konstrueret til at modstå brugen i uddannelses-laboratorier, være let at rengøre og samtidig være beskyttet mod utilsigtede udslip. Med indbygget ShockProtect ™ beskyttelse, håndterer vægtene store overbelastninger uden problemer.
Kapacitet 600 g, præcision 0,1 g Kapacitet 200 g, præcision 0,01 g
Har hvad der kræves for arbejde i både laboratoriet og i felten, og med mange forskellige uddannelses- og industrielle applikationer.
Kapacitet: 1000 g
Vejeinterval: 0,01 g
Nøjagtighed: 0,02 g 5 forskellige vejeenheder.
Med utallige funktioner er denne vægt ideel til laboratoriebrug. Vægten har display med letlæselige 24mm cifre, USB-stik og RS-232 interface til dataindsamling og nem kommunikation med printer og computer.
Kapacitet: 420 g
Vejeinterval: 0,001
Nøjagtighed: 0,001 g







Som Premium Consulting Partner hos tyske KERN er Scandidact klædt på til at vejlede jer i investeringer i vægte, mikroskoper og lign.
De fleste vægte kan købes med kalibreringscertifikat og kan naturligvis serviceres hos Scandidact.
Model PCB varenr. SKU22
Præcisionsvægt/bordvægt fra PCB-serien, max. vægt fra 0,1-10 kg.
Model Max. vægt (gram) Nøjagtighed
PCB
PCB
Model EMB varenr. SKU21
Startklar begyndervenlig vægt, der bruger justeringsprogrammet CAL.
Model Max. vægt (gram) Nøjagtighed
Model PNJ varenr. SKU125
FLERE VARIANTER


Præcisionsvægt / laboratorievægt i højeste kvalitet fra KERN med tællefunktion - ideel til mobilt brug.
Model EWJ varenr. SKU124
Laboratorievægt i højeste kvalitet fra KERN med høj præcision.
Model

FLERE VARIANTER




Basismikroskop med integreret kamera og LCD-skræm. Egner sig særligt godt til elevbrug på skoler og gymnasier, da det er robust og lavet af kvalitetsmaterialer, og samtidig udelukkende indeholder de nødvendigste egenskaber, hvilket gør det særdeles prisvenligt. Vi anbefaler derfor dette mikroskop til både folkeskole- og gymnasieniveau.
Denne model har fast kondensor, indstilleligt objektbord og tre akromatiske objektiver (mulighed for et fjerde).
I stedet for okularer har mikroskopet en 7” LCD-skærm med indbygget 2,0 MP kamera. Skærmen giver mulighed for både livevisning af præparater, at gemme billeder og videoer samt tilbyder en grundlæggende målefunktion.

Mikroskop med digital skærm i stedet for okularer, som også giver mulighed for at gemme billeder og videoer direkte på TFkort. Mikroskopet er et robust kvalitetsmikroskop, ideelt til skole, studie og hobbyformål. Det leveres med genopladelige batterier, hvilket også gør det til et bærbart feltmikroskop. Vi anbefaler dette mikroskop til både folkeskole- og gymnasieniveau.
LED-belysningen leveres med en dæmper til variation af lysintensitet, sammen med en højdejusterbar Abbe-kondensor med irisblænde. Mulighed for mere end blot standard 4x, 10x og 40x-forstørrelse, da mikroskopet kan udvides til 1500x ved tilkøb.
Mikroskopet koaksial grov- og finindstilling samt et krydsbord med ergonomisk optimal indstilling, der tillader bevægelse både i dybden og til siderne. Alle dele er sikkert låst til mikroskopet og dækket af antibakteriel maling, mens der er påført svampehæmmende belægning på de optiske glasdele.
Mikroskopet kan tilsluttes strøm på tre forskellige måder: AA-batterier, genopladelige batterier og 230V.


Polarisationsmikroskopet er særligt velegnet til observationer, der kræver gennemlysning, eks. sten-slides. Med 40x, 100x og 400x forstørrelse og justerbar halogenbelysning 6v-20W.
Specifikationer:
• Optisk system: Finite, 160 mm
• Okular: WF 10x/18 mm (par), den ene med pointer
• Okulartubus: Trinokulært, ikke roterbart, 45° hældning. Med dioptrisk kompensation (±5). Tredje tubus til f.eks. digitalt kamera.
• Revolver med gummigreb, kugleleje og klikstop til 3 objektiver
• Objektiver: DIN akromatiske, 4x, 10x, 40x .
• Fokusering: Dobbelt koaksial grov- og finindstilling.
• Objektbord: Rundt roterbart ojektbord med skala. Ø: 125 mm med noniusskala. Monteret med bøjler.
• Kondensor: Abbe-kondensator N.A. 1.25 i centreret holder. Filterholder, blåt filter og irisblænde. Justerbar i højden.
• Belysning: Indbygget justerbar halogen belysning 20 W/6 V.
• Forstørrelse: 40x, 100x og 400x.
• Driftsspænding: 100 ~ 240 V/50 Hz med sikring.

Designet til til brug i laboratorier, faglokaler eller andre situationer, hvor præcise mikroskopbilleder er nødvendige, og hvor der kræves fleksibilitet i både opsætning og betjening. Leverer knivskarpe billede uden kvalitetsforringelse. Passer til de fleste mikroskoper og adaptere medfølger.
2 megapixels m/ HDMI
2 megapixels m/ HDMI, WiFi og autofokus





Mål: 18x18 mm. Pakke med 100 stk.

Med cirkelformet, vandtæt kammer.
Æske med 5 stk.
Mål: Ø22 cm, H10 cm.

Mikroskopet er et robust kvalitetsmikroskop, ideelt til skole, studie og hobbyformål. Det leveres med genopladelige batterier, hvilket også gør det til et bærbart feltmikroskop. Vi anbefaler særligt dette mikroskop til brug på folkeskole- og gymnasieniveau.
Den transmitterede LED-belysning leveres med en dæmper til variation af lysintensitet, sammen med en højdejusterbar Abbe-kondensor med irisblænde. Mikroskopet giver mulighed for mere end blot standard 4x, 10x og 40x-forstørrelse, men kan udvides til 1500x ved tilkøb.
Objektiverne er akromatiske standardobjektiver (DIN). Mikroskopet har et 360° roterbart trinokulært hoved, koaksial grov- og finindstilling samt et krydsbord med ergonomisk optimal indstilling, der tillader bevægelse både i dybden og til siderne. Alle dele er sikkert låst til mikroskopet og dækket af antibakteriel maling, mens der er påført svampehæmmende belægning på de optiske glasdele.

Mikroskopet kan tilsluttes strøm på tre forskellige måder: 230V, genopladeligt batteri og standard AA-batterier. Derved er mikroskopet flytbart og kan tilmed tages med i felten. Vores
Monokulært (SC-146)

og bordmikrotom
Praktisk håndmikrotom/bordmikrotom med justeringsgrad på 10 microns per klik. Leveres i flot trææske komplet med mikrotomkniv og skruetvinge.
Binokulært (SC- 146)

Farvesæt til mikroskopi. Hele 9 x 30 mL forskellige væsker og farver i pipetteflasker, samt en tom pipetteflaske.
Trinokulært (SC-146)

Objektglas med afslebne kanter.
Mål: 76 x 25 x 1 mm.
Pakke med 50 stk.

Overhud, Epidermis

Vores pakketape er lavet af papir, så vores foresendelser kan nu gå direkte i papirgenbrug, i modsætning til til papkasser med PVC-tape og metalklammer.
For at sikre, at vore forsendelser ikke går i stykker, kunne vi bruge metervis af skum og bobleplast. Det har vi valgt fra. I stedet genbruger vi pakkefyld og papkasser, som vi får fra vore leverandørerja, selv vore medarbejdere tager pap og fyld med på arbejde til genanvendelse. På den måde gør vi vores til ikke at rutte alt for meget med ressourcerne.



Vores BIO pakkefyld er 100% kompostérbart og fremstillet af GMO-frit, CO2neutralt majsstivelse produceret lokalt i Danmark. Fyldet opløses i vand på få minutter - brug det i komposten eller bland det i pottejorden!
Vi har minimeret antallet af vores tryksager og vælger tit den miljørigtige onlineversion. Vores årlige katalog trykkes på Svanemærket papir, som er fremstillet energieffektivt, og som lever op til skrappe krav til kemikalier - både i skoven og i trykkeriet. Endvidere er papiret lavet af lovligt, sporbart træ, hvor en andel er certificeret – og/eller af genbrugspapir.
Som en ekstra lille “glorie-pudser”, sendes vores Scandidacts vejledninger ikke sammen med produktet ved køb.
I stedet er alle vejledninger frit tilgængelige i webshoppen (f.eks. om Chlorella-alger, mikroplast, sten og bjergarter, osteløbe, vandrensning, CRISPR-teknologi, kombucha, bestrålede frø, majsfrø, UV- perler, biogasanlæg, chromosomer og mange, mange flere - og flere er på vej!).
En gave til jer og ikke mindst miljøet. Det var så lidt







Med mere end 5.000 varenumre har vi sikkert det, du lige står og mangler - hvis ikke, så kan vi sikkert skaffe eller udvikle det.
Kontakt os og hør mere: br@scandidact.dk eller tlf. 4913 9333.












Scandidact ApS
Skovdalsvej 4 · 8300 Odder info@scandidact.dk www.scandidact.dk/naturfag Tlf. (+45) 4913 9333

